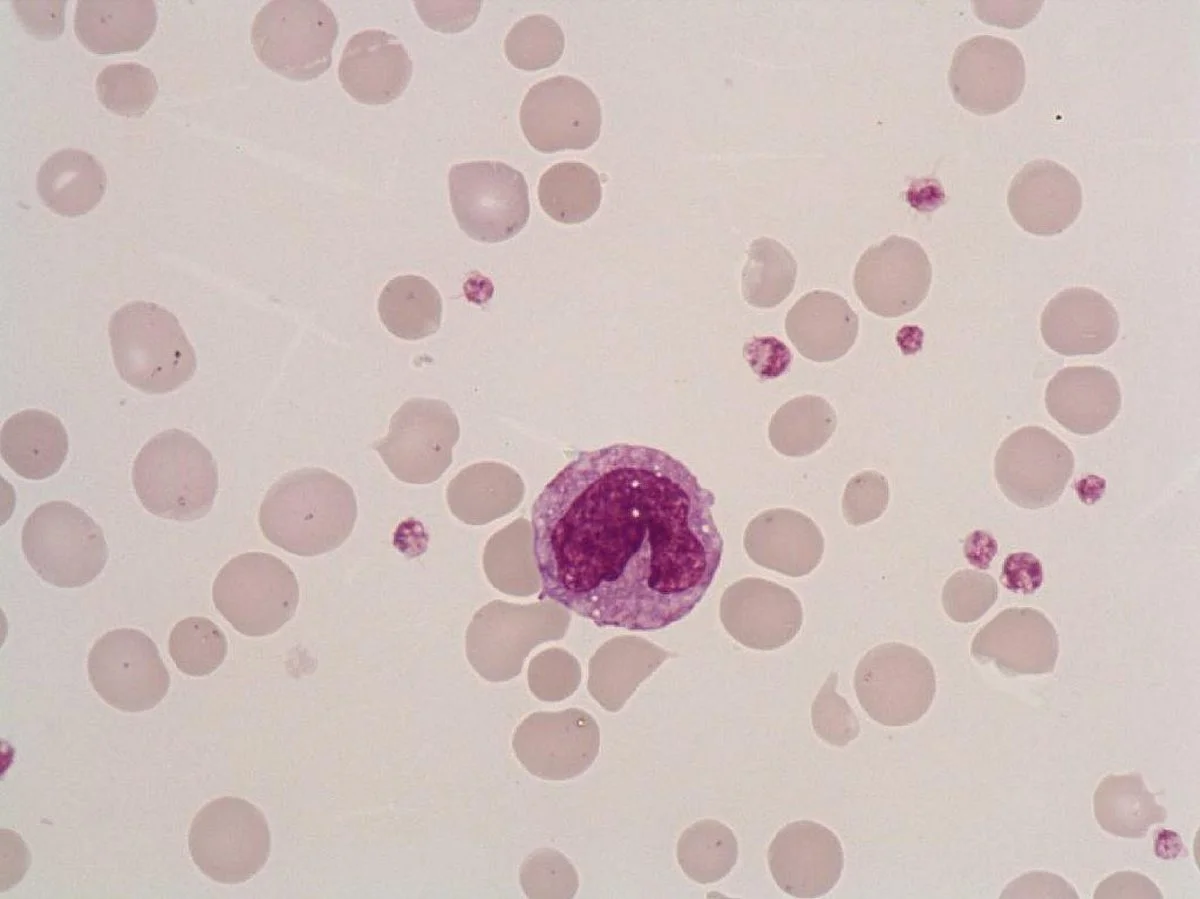
<ul><li><p>they can differentiate into macrophages and dendritic cells to engulf and destroy pathogens</p></li><li><p>initiate the inflammatory and anti-inflammatory processes </p></li><li><p>originate in bone marrow from monoblasts</p></li></ul><p></p>

lab practical 2
1/83
There's no tags or description
Looks like no tags are added yet.
Name | Mastery | Learn | Test | Matching | Spaced | Call with Kai |
|---|
No analytics yet
Send a link to your students to track their progress
84 Terms
basophil
-play a key part in allergic reactions by releasing histamine when allergens bind to antibodies ont he surface. they also release cytokines that activate other immune cells, linking adaptive and innate immunity
-originate in bone marrow from hematopoetic stem cells

monocyte
they can differentiate into macrophages and dendritic cells to engulf and destroy pathogens
initiate the inflammatory and anti-inflammatory processes
originate in bone marrow from monoblasts
lymphocyte
-produce antibodies that neutralize pathogens
T lymphocytes stimulate differentiation of B-cells into antibody- producing cells, kill infected cells and cancerous cells, and control and suppress immune responses

eosinophil
-defend against parasite infections by using enzymes and toxic proteins, modulate allergic reactions and help with tissue repair by secreting growth factors
-originate in the bone marrow from multipotent progenitor cells

neutrophils
-the first line of defense in the immune system
-can phagocytize foreign invaders, release granules that can kill pathogens, and form NETs that capture and kill microbes
-originate in the bone marrow from hemotopoietic stem cells

role innate immune system would play in response to an abraison, beginning with initial wound
upon wound the innate immune system acts as the immediate, non-specific first responder to protect against infection and initiate repair
the process by which the adaptive immune system defends the body against viruses
using specialized lymphocytes to target specific viral antigens. plasma cells create antibodies, plasma cells are made by B cells. involves cytotoxic T cells and helper T cells
counting for RBC
count the number of red blood cells in the four corners and middle of the center
counting for WBC
count the number of white blood cells in the four corners
counting cells
count the cells that are touching the left and top boundry, omit the cells that are touching the bottom and right side boundaries
calculating average cell number
multiply average cell number by the dilution factor
size of individual square
0.25 mm
size of larger four corner square
1 mm
multiplication factor
= (number of cells from 5 squares) x (5) x (500 dilution factor) x (10)
what is anemia
a condition where there is a lack of healthy red blood cells or hemoglobin in the blood. hemoglobin is a protein in the RBC that carries oxygen throughout the body. WIthout sufficient healthy RBCs or hemoglobin the body is unable to get enough oxygen
who won american idol in 2011
Scotty McCreery
what is it called when the body can respond to all physical stresses
homeostasis
what is the process to create white blood cells
Leukopoiesis
what is the hormone produced by the adrenal gland
adrenalin
what does systolic blood pressure represent?
the highest pressure in the artery, produced by the hearts contraction (systolic) phase, normal=120 mmHg
what does diastolic blood pressure represent?
the lowest pressure in the artery, produced during the hearts relaxation (diastolic) phase, normal= 80 mmHg
a patient has a BP reading of 170/110-, how can you explain the inability to obtain a third reading
the buildup of fatty deposits along the artery walls, making it hard to read the blood pressure. Creating constant noise, the Korotkoff sounds cant be detected. The artery will not open/ close properly, so blood flow with not be fully functioning.
normal components of an EKG
p wave, QRS complex, T wave
p wave
represents the spread of electrical activity ( wave of negativity) over the atria after initial depolarization of the SA node
QRS complex
the spread of negativity wave (depolarization) through the ventricular masculature. A small amount of atrial repolarization also occurs at the same time
T wave
represents the repolarization of the ventricular musculature. it is of longer duration and lower amplitude than the depolarization wave (QRS complex), which indicates that the ventricular repolarization process is less syncronized and slower than the depolarization process
how do the walls of the atria compare to the walls of the ventricles? why are they different?
the atrium walls are thinner than the ventricles and experience lower pressure. The ventricles have thicker walls because they pump blood out of the heart, generating much higher pressure.
Residual volume (RV)
The volume of air remaining in the lungs after a maximum, forced exhalation
expiratory reserve volume (ERV)
The maximal volume of air that can be forcibly exhaled after a normal, quiet expiration
Tidal volume
the volume of air inhaled or exhaled during a single, normal respiratory cycle at rest
pure water is ______ to blood
hypotonic
water has a much lower concentration of solutes, water will move into the blood cells through osmosis, causing them to swell
gatorade is ______ to blood
isotonic
gatorade has a similar concentration of carbs and electrolytes, it is designed to be isotonic so that it can hydrate and replenish energy during exercise, cell remains normal
salt water is _____ to blood
hypertonic
it has a higher concentration of salt (solutes) than blood, water moves out of the blood cells through osmosis, causing them to shrink
hypermetropia
long- sightedness, far objects are clear, close objects are blurry
myopia
near sightedness, distant objects are blurry, close objects are clear
presbyopia
gradual loss of the eye's ability to focus on close objects
zonulues
attach lens to cilary muscle
lens
blends light to focus it on the retina
optic disk
region where optic nerve and blood vessels leave the eye
central retinal artery and vein
emerge from center of optic disk
fovea
region of sharpest vision
retina
layer that contains photoreceptors
sclera
connective tissues
ciliary muscle
contraction alters the curvature of the lens
pupil
changes the amount of light entering in the eye
tapetum lucidum
a reflective tissue layer located behind the retina in the eyes of many vertebrates, acting as a "mirror" to reflect light back through the retina
why do near points become longer with increasing age
the lens in the eye loses the flexibility required to adjust its focus on close objects.
what causes the blind spot in the visual field
there are no cones for visual reception in the blind spot area, the optic disk lacks photoreceptors
what does a 20/20 vision rating mean
the ability to see an object clearly from 20 feet away what a normal person can see 20 feet away.
where is the blind spot located in relation to fovea
15 degrees on nasal side of fovea
explain the physiological mechanism that produces these after image colors
after image colors are produced by retinal fatigue of photoreceptor cones after prolonged stimulation by a specific color, followed by an opponent process in the visual system
what happens to respiratory rhythm following hyperventilation
the respiratory system slows down, becomes shallower or temporarily ceases altogether
transport of materials across membranes occurs by several processes in the kidney, give one example of each transport process
filtration- in the golmerulus and bowmans capsule
example- glomerulus acts as a filter, allowing water, electrolytes and urea to pass into the nephron while blocking proteins and blood cells
two symptoms present in diabetes millitus are hyperglycemia and diuresis. what causes this increased urine output?
diabetes millitus is caused by insulin resistance. cells begin to not respond normally to insulin signaling which results in less glucose removed by the cells for glycolysis, increasing blood glucose in the body
the kidneys can only resorb a set amount of glucose from the blood, so in the case of hyperglycemia caused by diabetes militus, glucose has to be extreted in the urine. This increases the osmolarity of the urine, causing less water to be reabsorbed, which leads to more water being excreted increasing urine production
what is respiratory rate
the number of breaths a person takes per minute, usually measured at rest by counting how many times the chest rises. It is a key vital sign used to assess overall health
hyperventiation
rapid, deep breathing—often called overbreathing—that causes excessive loss of carbon dioxide (CO2) from the blood
explain the difference in a persons respiratory movements when hyperventilation takes place in and out of a paper bag
Hyperventilating into a paper bag forces the person to re-inhale carbon dioxide (CO2) rich air, slowing the rapid, shallow breathing cycle and raising blood levels to counteract lightheadedness. Without the bag, hyperventilation causes excessive loss, causing continued rapid breathing, vasoconstriction, and potential fainting
what is pulmonary fibrosis
a chronic, progressive lung disease where tissue deep in the lungs becomes scarred, thick, and stiff, making it difficult to breathe and transfer oxygen into the bloodstream
what happens to the respiratory system with pulmonary fibrosis
causes progressive scarring and thickening of lung tissue, reducing lung elasticity and making them stiff. This damage impairs the lungs' ability to expand, reducing vital capacity, and hinders oxygen transfer into the bloodstream.
what is hypertension
is a chronic condition where the force of blood against artery walls is consistently too high
hypertension blood pressure
140/90 or higher caused by unhealthy diet, physical inactivity, genetics, age, secan older
an older patient comes in complaining about a lack of vision near sidedly, what would be your diagnosis and why does this happen
presbyopia
conjunctiva
covers the cornea with a thin layer of epithelium
fovea centralis
contains only the cones and provides the best focus of an image
active transport
occurs in proximal convoluted tubules, moves substances against concentration gradients to reabsorb nutrients or excrete waste, primarily using ATP
osmosis
in the collecting duct, which reabsorbs water from filtrate into interstitial fluid
diffusion
occurs primarily within the nephron—specifically the glomerulus and renal tubules—where passive movement of solutes (like urea) and water occurs along concentration gradients. Examples include the diffusion of water/solutes out of glomerular capillaries and the passive reabsorption of urea from tubules
lysed cells
cells whose outer membranes have been broken down or destroyed (oncolysis) to release internal materials like protein, DNA, or RNA

non lysed cells
intact, living, or functional cells that have not been broken open (lysed) by mechanical, chemical, or biological means
what is a heart murmur and what causes it
an extra sound during a heart beat, caused by turbulent blood flow in the heart
MAP=
DP+1/3(SP-DP)
pulse pressure
the difference between the systolic and diastolic pressures, normal =40mmHg
mean blood pressure
diastolic pressure plus one third of the pulse pressure, the average effective pressure forcing blood through the circulatory system,. normal =90-100 mmHg
what produces the systolic korotkoff sound
the turbulent flow of blood and rapid vibrations of the arterial wall as it snaps open
why does the sound disappear at the end of a measurement (phase 4)
the pressure in the blood pressure cuff has dropped below diastolic pressure
if your TPR=1, what is your CO in the sitting position
93 mmHg
BP= 120/80 MAP=CO*TPR
MAP= 80 + 1/3(120-80) = 93 mmHG
explain the physiological mechanism operating in the cold pressure test
it acts as a physical stressor, triggering a rapid sympathetic nervous system discharge
interventricular septum
thick muscular wall seperates the right and left ventricles